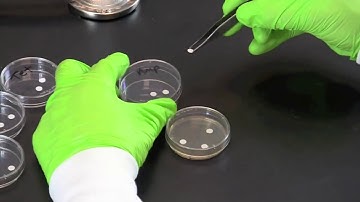
How To Perform a Disk Diffusion Test (Modified Kirby-Bauer Test)

⬇ DOWNLOAD NOW
Kalau muncul iklan pop-up, tutup lalu klik tombol kembali
Download lagu Testing an Antibiotic Using a Disk Diffusion Assay - Kirby Bauer Method secara gratis hanya untuk keperluan promosi. Dukung artis favorit kamu dengan membeli musik original di iTunes atau platform resmi lainnya.
 Kirby Bauer Disk Diffusion Method
Kirby Bauer Disk Diffusion Method
 Disc Diffusion (Kirby-Bauer) Antimicrobial Susceptibility Testing
Disc Diffusion (Kirby-Bauer) Antimicrobial Susceptibility Testing
 How to do a Kirby-Bauer Disk Diffusion Antimicrobial Susceptibility Test
How to do a Kirby-Bauer Disk Diffusion Antimicrobial Susceptibility Test
How To Perform a Disk Diffusion Test (Modified Kirby-Bauer Test)
How To Perform a Disk Diffusion Test (Modified Kirby-Bauer Test)
 Kirby Bauer Assay - Techniques Demonstration
Kirby Bauer Assay - Techniques Demonstration
 Kirby Bauer - Disc Diffusion Method for Antibiotic Susceptibility Testing
Kirby Bauer - Disc Diffusion Method for Antibiotic Susceptibility Testing
 Antibiotic Sensitivity testing
Antibiotic Sensitivity testing
 The Kirby-Bauer Method for Antibiotic Susceptibility (with examples)
The Kirby-Bauer Method for Antibiotic Susceptibility (with examples)